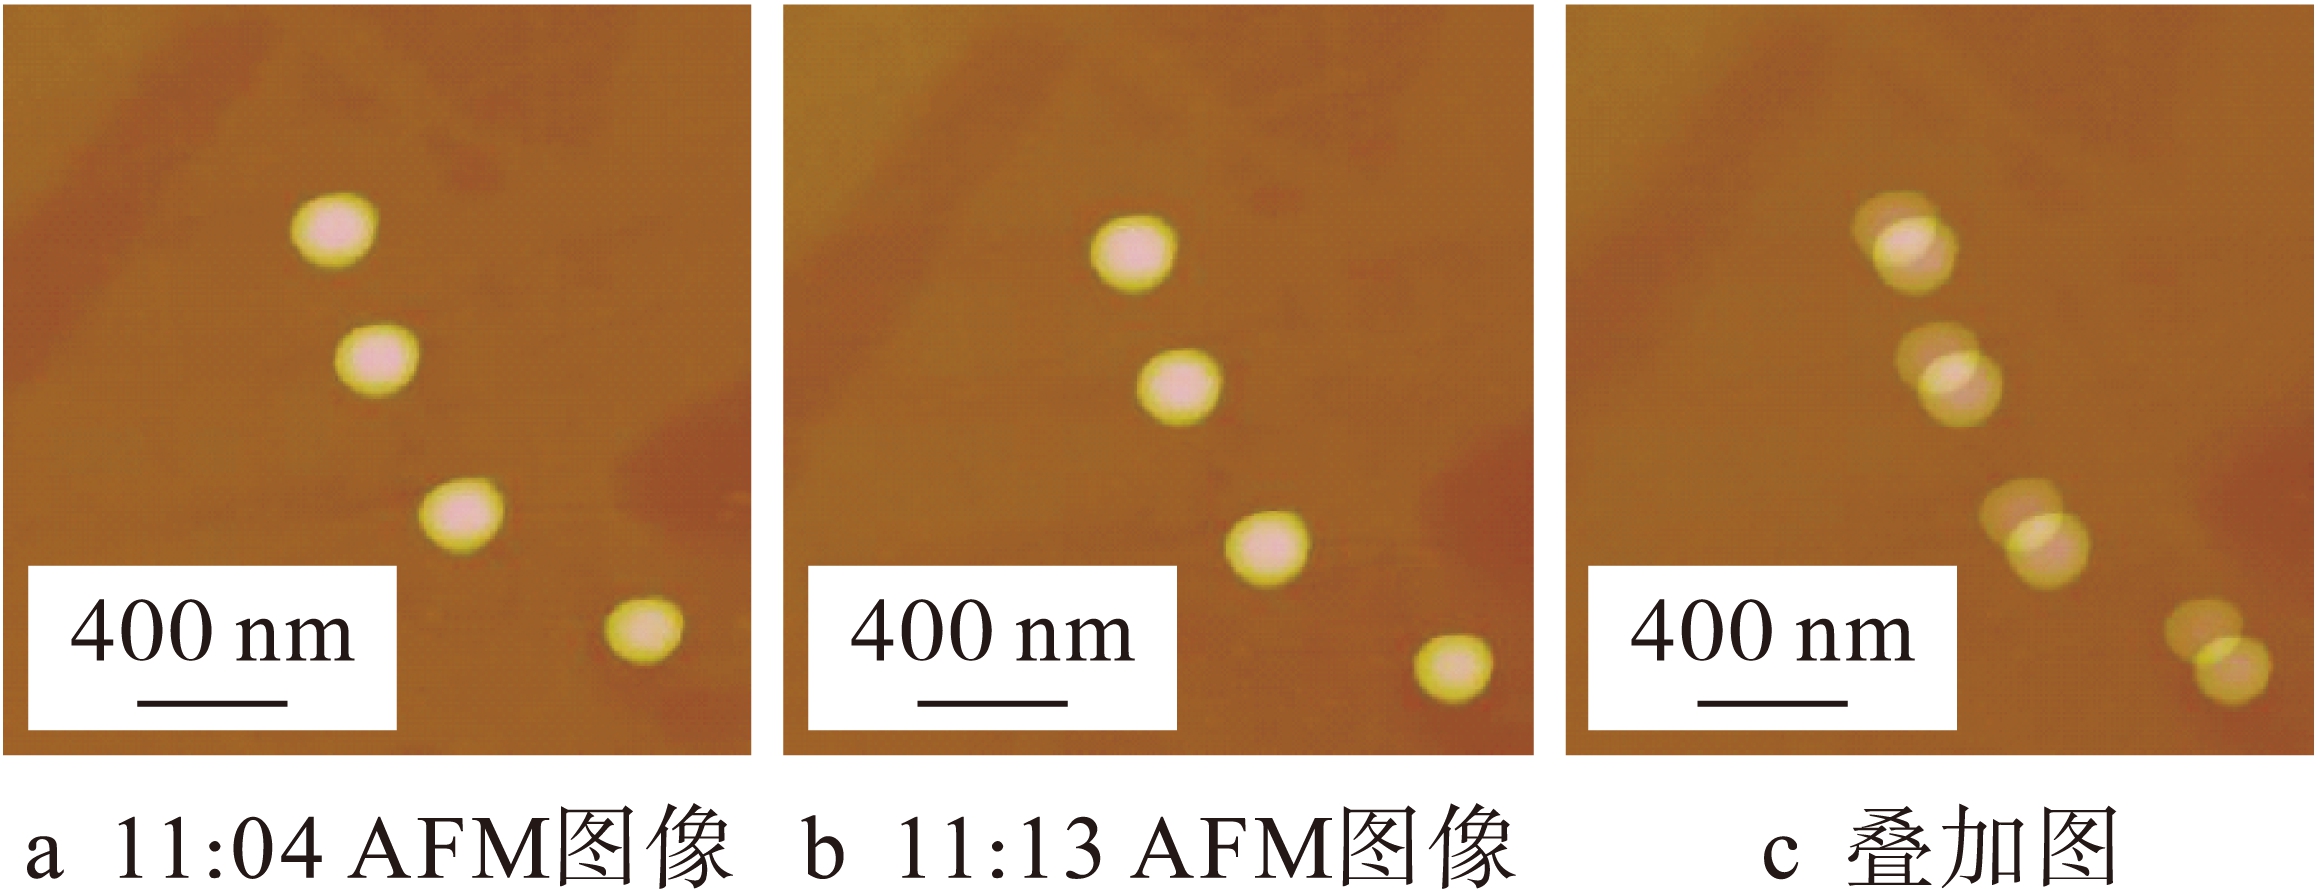

侯 静1,2, 袁 帅1,3, 许 可1,3, 李孟歆1, 吴成东2
(1. 沈阳建筑大学 信息与控制工程学院, 沈阳 110168; 2. 东北大学 信息科学与工程学院, 沈阳 110004; 3. 中国科学院 沈阳自动化研究所机器人学国家重点实验室, 沈阳 110016)
摘 要:由于压电陶瓷机构的非线性及系统温度漂移等因素使AFM探针难以精确定位到被操作物体,从而导致跳针或滑落现象,阻碍了AFM纳米操作的发展.为了解决该问题,提出了基于局部扫描的实时反馈纳米操作系统.系统以样品表面的纳米颗粒作为路标并对其进行持续观测,解决了系统温漂引起的探针定位误差问题,提高了探针的定位精度;在纳米操作过程中采用局部扫描策略,通过对操作后的结果进行快速扫描,实现了实时反馈纳米操作系统.实验结果验证了该纳米操作实时反馈系统在大温漂条件下操作的有效性.
关 键 词:局部扫描; 温漂补偿; 纳米操作; 实时反馈; 原子力显微镜; 路标观测; 快速扫描; 有效性
纳米科技的最终目标是在纳米尺度上使用单个原子、分子制造功能器件或系统的科学技术.原子力显微镜(atomic force microscope,AFM)的出现对纳米科技发展产生重要的促进作用,高分辨率和操作精度使其成为纳米操控的主要工具[1-3].但AFM最初是用于进行纳米观测的工具,故进行纳米操作时,每一步的操作结果都需要重新成像来验证,这种扫描—规划—操作—扫描的操作模式效率低下,严重阻碍了AFM纳米操作的可靠性和效率[4].Li应用增强现实技术,利用操作过程中的实时力信息更新操作界面进行纳米粒子操作,但没有解决实时视觉反馈的离线模型可信度不高的问题[5];Liu提出了局部扫描的方法实时观测操作结果[6],但是由于操作中存在的不确定因素导致纳米操作很难达到期望位置,需要操作者连续多次操作才能完成预期目标.研究者提出了多种方法来进行纳米操作,Zhao采用连续推动的方式操作粒子[7];Xu提出了连续并行推动操作方式[8],但无法解决探针相对于被操作物体的精确定位问题.定位影响因素主要包括探针驱动器的非线性和系统温漂,前者可通过增加位移传感器进行闭环精确控制[9-10],但系统温漂在探针任务空间引起的定位误差依然没有得到解决.
针对系统温漂引起AFM探针在任务空间定位误差的问题,本文提出了基于局部扫描的路标观测方法,通过观测样品表面上的特征物(如纳米颗粒的位置漂移变化)对AFM图像进行补偿,实时修正探针在任务空间中的位置.在纳米操作过程中,针对离线模型可信度不高的问题,本文借助基于局部扫描的观测方法,对操作后的结果进行快速扫描,从而实现实时反馈操作结果,提高操作效率.文中构建了基于局部扫描的纳米操作实时反馈系统,并利用搭建的操作平台对纳米颗粒进行推动操作实验,验证了采用局部扫描的实时反馈方法,提升了探针在任务空间中定位、操作的性能,提高了纳米操作的效率.
1.1 局部扫描的概念
为了提高操作效率,在纳米操作中可采用局部扫描策略完成操作空间的信息更新.局部扫描就是通过简单的几条扫描线完成对路标的快速实时观测.图1a为扫描纳米颗粒的示例,两条扫描线就能确定其位置.图1b中第1条扫描线沿着L1进行扫描,扫描线与颗粒的边界形成两个交点P1和P2,沿着P1和P2垂直的方向且过其中点再次进行扫描,扫描线L2与颗粒的边界形成另外的两个交点Q1和Q2,那么颗粒实际位置O就在Q1和Q2的中点处.通过将该颗粒作为参考路标,就可以标定图像漂移后的新位置.由于仅需要两条线就能唯一确定纳米颗粒的位置,因而局部扫描通常在几十毫秒内完成,从而实现参考路标的实时观测.

图1 局部扫描策略示意图
Fig.1 Schematic local scanning strategy
1.2 基于局部扫描的温漂补偿方法
基于AFM的纳米操作是以预先扫描的图像作为先验知识来指导操作,但由于AFM操作系统的温度变化、机械结构和各部件的热膨胀系数等因素的影响,纳米物体的实际位置相对于初始成像会随时间发生漂移.图2是纳米颗粒连续扫描图,图2a、b两图的成像时间间隔为11 min,图2c为两者的叠加图像,结果表明纳米颗粒在扫描过程中向右、向上漂移,这种漂移对基于初始视觉信息指导的纳米操作影响是非常严重的,难于实现较高的控制精度.
图2 纳米粒子连续扫描图
Fig.2 Continuous scanning images of nanoparticles
针对这一问题,本文提出基于局部扫描的温漂补偿方法,其基本原理是将扫描图像上的某特征点设置为路标,在操作过程中通过局域快速扫描方式来实时获取路标在图像中的位置变化,实现温漂的检测,并通过坐标变化的方式,将该温漂位移补偿到操作控制量上,从而达到操作过程对系统温漂的补偿.图3a是预先扫描的一幅图像,由于存在系统温漂,通过连续扫描确定在任务空间中该图像的位置将向右上角漂移,将图中的纳米粒子P1确定为路标;图3b是观测纳米颗粒P1的两条快速扫描线,通过局部扫描颗粒P1可以获得温漂的补偿位移为x方向97 nm、y方向141 nm,将其补偿到前一刻扫描图像上,如图3c中黑色部分所示,则可以得到校正后的该时刻图像;图3d是重新扫描的AFM实际图像结果,将图3c、d两图比较可以看出,补偿后图像校正的结果与重新扫描的图像一致,验证了以纳米颗粒作为参考路标,采用局部扫描方法进行温漂补偿的有效性.

图3 基于局部扫描的温漂补偿示意图
Fig.3 Schematic thermal drift compensation based on local scanning
基于AFM的纳米操作是通过AFM的终端执行器,即一根极细的探针接触纳米物体来实现的,样本和针尖的接触面积很小,因此探针只能对样本施加点式作用力,从而导致操作过程中经常出现探针滑过操作物体的现象,即粒子丢失造成操作任务的失败.基于上述问题,本文构建了基于局部扫描的实时操作反馈策略,该策略通过在操作过程中不断应用局部扫描策略确定纳米颗粒的真实位置,并对系统存在的温漂进行补偿,将更新后的位置信息进行反馈来修正粒子在视觉反馈界面中的位置,从而实现对操作粒子的实时跟踪,保证纳米粒子能够被操作到期望的位置.由于纳米颗粒的位置状态可由它的中心位置和半径决定,且纳米颗粒的半径可通过预扫描图像获取,因此,在操作中只需要确定纳米颗粒的中心位置便能得到它的真实位置.
图4为具有实时反馈导向的任务空间中纳米操作过程示意图.

图4 任务空间AFM纳米操作
Fig.4 AFM nanomanipulation in task space
图4a中Oo代表操作前某一时刻纳米颗粒发生的位置;Om代表操作后在视觉反馈界面中显示的纳米颗粒模型位置;蓝色箭头代表纳米颗粒被操作的方向.由于模型的不确定性,在操作过程中纳米颗粒的真实位置与视觉反馈现实的位置并不一致,实际中心位置在图中的Oa点.为了获取Oa的位置,需要先沿着推动方向l0扫描,如纳米颗粒没有被发现,扫描线再沿着与l0平行的方向且与其间隔为3r/2的l1或l2线进行扫描,直到纳米颗粒被发现,此时扫描线和颗粒的边界形成两个交点,通过这两个交点的中点,再沿着l4扫描线(垂直于l0、l1与l2)进行扫描,与纳米颗粒的边界形成另外两个交点,则这两个交点的中点就是实际纳米颗粒的中心位置Oa.图4b是显示局部扫描时扫描纳米颗粒不同位置时的3D仿真图.图4c~f显示了采用局部扫描方法进行纳米操作的视觉反馈过程,图4c是操作前的纳米颗粒分布图,箭头方向表示纳米颗粒P0的推动方向;图4d是纳米颗粒P0推动后的期望位置
,即未采用局部扫描时实时视觉反馈界面显示的粒子位置;图4e是纳米颗粒P0在推动后,通过局部扫描方法实时反馈后获得的更新位置P″0;图4f是纳米颗粒推动后重新进行AFM扫描后纳米粒子的实际位置.将视觉反馈界面图4e和AFM扫描图4f相对比,可以看出纳米颗粒P0的位置是一致的,验证了基于局部扫描实时反馈操作策略的有效性.
基于局部扫描的实时反馈操作策略中探针运动路径的规划执行可编程操作,因此,应用机器人监控理论方法和纳米操作特点,建立了基于AFM和人机交互界面的实验系统,如图5所示.

图5 实时反馈纳米操作系统
Fig.5 Real-time feedback nanomanipulation system
该系统以美国Veeco公司Dimension 3100为基础,通过三台计算机实现对AFM执行机构,增强现实系统与实时控制模块的控制.从系统结构图上可以看到,数据采集卡(data acquisition,DAQ)将电压信号直接输出到改造后的AFM控制器上以驱动探针运动,因而通过该计算机可以实现探针的实时高速控制.在局部扫描过程中,可以获取施加在压电陶瓷管Z方向的电压信号,该信号代表了沿着扫描轨迹的样品表面形貌信息,通过DAQ卡采集得到沿扫描轨迹的形貌信息后,可以实现真实纳米操作结果的获取和基于路标的定位.
图6为基于局部扫描的实时反馈纳米操作系统功能示意图.AFM执行机构能够通过控制器接收主控计算机与实时数据处理模块的控制命令,完成样品的扫描观测与纳米操作.主控计算机用于扫描成像,并将图像数据传送到增强现实系统中.实时数据处理模块根据增强现实系统的命令,实时生成探针局部扫描的路径规划数据,将其发送给AFM控制器;同时接收AFM控制器的扫描数据,并将其反馈到增强现实系统的实时反馈界面中,供操作人员进行实时纳米操作.

图6 实时反馈纳米操作系统功能图
Fig.6 Function diagram of real-time feedback nomanipulation system
4.1 样本制备
将半径为100 nm的聚氯乙烯纳米小球溶液用去离子水进行稀释,取少许溶液滴在干净的CD基底上,氮气吹干后,静置3 h以上方可进行操作.
4.2 实验结果
本实验平台为自组建的基于局部扫描的实时反馈纳米操作系统,探针为MikroMasch公司的NSC15/AIBS,将制备好的纳米颗粒作为操作对象,使用AFM探针构建纳米结构.
为了说明基于局部扫描的实时反馈纳米操作系统的有效性,对预制好的聚氯乙烯纳米小球样本进行连续成像及温漂补偿,以5次补偿过程为例,统计结果如图7~9所示.图7为不同时间节点情况下对纳米颗粒样本进行AFM的连续扫描结果图,扫描区域为3 μm×3 μm.从连续扫描图中粒子P1的位置变化可以看出,在AFM扫描过程中,系统存在较大的温漂,若对此种情况不进行处理,直接进行纳米粒子的操作,则很有可能出现AFM探针无法作用到指定的位置,甚至出现探针与纳米粒子脱离的现象,从而导致失败的操作结果.基于局部扫描的实时反馈纳米操作系统能够实时对扫描图像进行温漂补偿,各时间节点扫描图像的补偿结果如图8所示.图8中各图的黑色边框部分为温漂计算后的补偿位移,各图的补偿结果不相同体现了补偿的实时性能.将补偿后的预测图像与真实的AFM扫描图像进行对比,即图8a与图7b、图8b与图7c、图8c与图7d、图8d与图7e进行对比,可以看出补偿后的预测图像能够反映真实的AFM扫描图像,故在此基础上进行相应的纳米操作,能够大大提高操作的可靠性和操作效率.图9为基于局部扫描的纳米操作实时反馈系统完成的大温漂下纳米装配任务操作结果.图9a是操作界面的初始图像;图9b为实时显示的纳米操作结果;图9c是操作前初始的AFM图像;图9d是操作完成后重新扫描得到的AFM图像.从图9b和图9d的实验结果可以看出,操作界面显示的实时操作结果与真实的操作结果几乎完全匹配,说明本文提出的基于路标的温漂实时检测和补偿方法能够克服大温漂情况下探针定位不准确问题.基于局部扫描实时反馈纳米操作系统针对纳米颗粒的区域,采用局部扫描的方式,提高了视觉反馈界面实时反馈的可信度,能够准确、高效地将纳米粒子操作到期望位置,能够实现纳米器件的制造与装配.

图7 不同时间节点的AFM连续扫描图
Fig.7 AFM continuous scanning images at different time nodes

图8 不同时间节点的温漂补偿结果图
Fig.8 Thermal drift compensation images at different time nodes

图9 实时反馈纳米操作系统操作结果
Fig.9 Manipulated results of real-time feedback nanomanipulation system
纳米装配操作过程中,缺乏有效的方法来确定纳米物体的实时位置仍然是纳米结构和纳米器件制造过程中面临的主要问题之一.本文针对上述主要问题建立了基于局部扫描的实时反馈纳米操作系统,实现子系统计算机之间的实时数据传输以及局部扫描的路标观测与实时操作结果反馈界面.针对温漂引起探针在实时任务空间中的探针定位误差,采用局部扫描路标的方式补偿了样品相对于探针的温漂偏移.在此基础上,利用局部快速扫描方法实时反馈纳米操作的结果,修正离线模型的视觉反馈误差,提高纳米操作实时反馈的可信度,增加探针操作控制的鲁棒性,提升AFM纳米操作的效率和有效性.
参考文献(References):
[1]Suenne K,Farbod S,Daniel R,et al.Controlled AFM manipulation of small nanoparticles and assembly of hybrid nanostructures [J].Nanotechnology,2011,22(11):1-6.
[2]Wu S,Fu X,Hu X D,et al.Manipulation and behavior modeling of one-dimensional nanomaterials on a structured surface [J].Applied Surface Science,2010,256(14):4738-4744.
[3]Yuan S,Luan F J.Reconstruction of an AFM image based on estimation of the tip shape [J].Measurement Science and Technology,2013,24(10):105-108.
[4]侯静,吴成东,董再励,等.基于AFM的虚拟纳米手操作策略研究 [J].仪器仪表学报,2013,34(5):1167-1172.
(HOU Jing,WU Cheng-dong,DONG Zai-li,et al.Research on virtual nano-hand strategy based on AFM [J].Chinese Journal of Scientific Instrument,2013,34(5):1167-1172.)
[5]Li G Y,Xi N,Chen H P,et al.“Videolized” atomic force microscopy for interactive nanomanipulation and nanoassembly [J].IEEE Transctions on Nanotechno-logy,2005,4(5):605-615.
[6]Liu L Q,Luo Y L,Xi N,et al.Sensor referenced real-time videolization of atomic force microscopy for nanomanipulations [J].IEEE/ASME Transctions on Mechatronics,2008,13(1):76-85.
[7]Zhao W,Xu K M,Qian X P,et al.Tip based nanomanipulation through successive directional push [J].Journal of Manufacturing Science and Engineering,2010,132(3):0309091-0309099.
[8]Xu K M,Kalantari A,Qian X P.Efficient AFM based nanoparticle manipulation via sequential parallel pushing [J].IEEE Transactions on Nanotechnology,2012,11(4):666-675.
[9]Habibullah,Pota H R,Petersen I R,et al.Creep,hysteresis,and cross-coupling reduction in the high-precision positioning of the piezoelectric scanner stage of an atomic force microscope [J].IEEE Transactions on Nanotechnology,2013,12(6):1125-1134.
[10]Rana M S,Pota H R,Petersen I R.The design of model predictive control for an AFM and its impact on piezo nonlinearities [J].European Journal of Control,2014,20(4):188-198.
(责任编辑:景 勇 英文审校:尹淑英)
HOU Jing1, 2, YUAN Shuai1, 3, XU Ke1, 3, LI Meng-xin1, WU Cheng-dong2
(1. School of Information and Control Engineering, Shenyang Jianzhu University, Shenyang 110168, China; 2. College of Information Science and Engineering, Northeastern University, Shenyang 110004, China; 3. State Key Laboratory of Robotics, Shenyang Institute of Automation, Chinese Academy of Sciences, Shenyang 110016, China)
Abstract:Due to such factors as the nonlinearity of piezoelectric ceramic device and the thermal drift in the system, the AFM tip is difficult to accurately position to the object to be manipulated, which leads to the tip skipping or slippage phenomenon and hinders the development of AFM nanomanipulation. In order to solve this problem, a real-time feedback nanomanipulation system based on local scanning was proposed. In the proposed system, the nanoparticles on the surfaces of samples were taken as a landmark and continuously observed. Moreover, the problem of tip positioning error caused by the thermal drift of system can be solved, and the positioning accuracy of the tip gets improved. The local scanning strategy was used during the nanomanipulation process, and the real-time feedback nanomanipulation system was realized through the rapid scanning of manipulated results. The experimental results demonstrate the validity of the proposed real-time feedback nanomanipulation system under large thermal drift condition.
Key words:local scanning; thermal drift compensation; nanomanipulation; real-time feedback; atomic force microscope; landmark observation; rapid scanning; validity
收稿日期:2015-04-10.
基金项目:国家自然科学基金青年基金资助项目(61305125); 中国博士后科学基金资助项目(2013M530955,2014T70265).
作者简介:侯 静(1980-),女,辽宁兴城人,副教授,主要从事智能算法及纳米操控技术等方面的研究.
doi:10.7688/j.issn.1000-1646.2016.01.13
中图分类号:TN 16
文献标志码:A
文章编号:1000-1646(2016)01-0074-06
*本文已于2015-09-15 00∶01在中国知网优先数字出版. 网络出版地址: http:∥www.cnki.net/kcms/detail/21.1189.T.20150915.0001.010.html